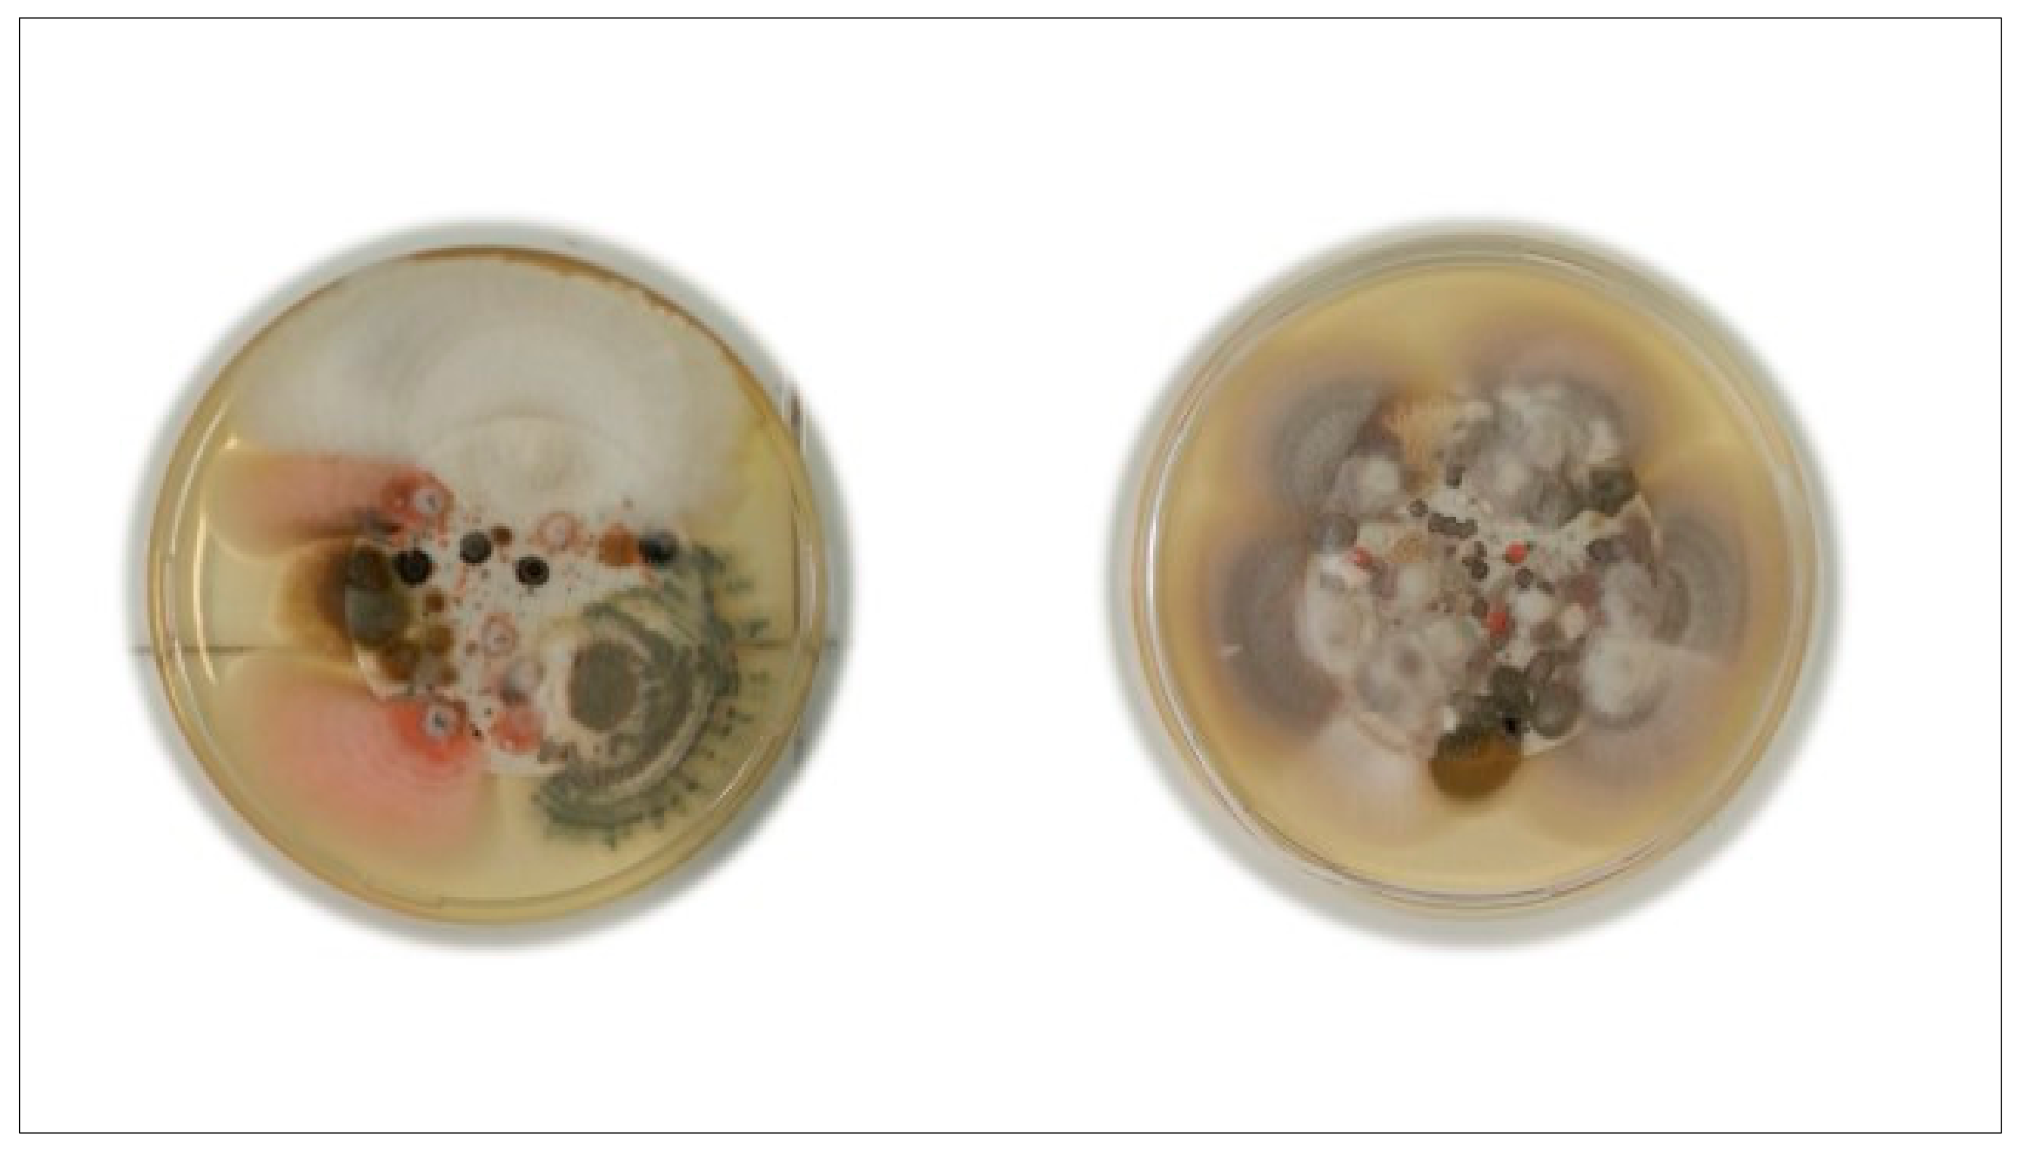
Pathogens 09 00783 g001

Occurrence of Fungi in the Potable Water of Hospitals: A Public Health Threat
Abstract
1. Introduction
2. Results
3. Discussion
4. Materials and Methods
4.1. Study Design
4.2. Water Sampling and Mycology Investigation
4.3. Fungal Identification
4.4. Statistical Analysis
5. Conclusions
Author Contributions
Funding
Conflicts of Interest
References
- Lovero, G.; De Giglio, O.; Montagna, O.; Diella, G.; Divenuto, F.; Lopuzzo, M.; Rutigliano, S.; Laforgia, N.; Caggiano, G.; Montagna, M.T. Epidemiology of candidemia in neonatal intensive care units: A persistent public health problem. Ann. Ig. 2016, 28, 282–287. [Google Scholar] [PubMed]
- Suleyman, G.; Alangaden, G.J. Nosocomial Fungal Infections: Epidemiology, Infection Control, and Prevention. Infect. Dis. Clin. N. Am. 2016, 30, 1023–1052. [Google Scholar] [CrossRef] [PubMed]
- Mosayebi, M.; Eslamirad, Z.; Hajihossein, R.; Ghorbanzadeh, B.; Shahverdi, M.; Didehdar, M. Evaluating of fungal contamination in hospital wet cooling systems in Markazi province, Central Iran. J. Mycol. Med. 2017, 27, 334–338. [Google Scholar] [CrossRef] [PubMed]
- Diekema, D.; Arbefeville, S.; Boyken, L.; Kroeger, J.; Pfaller, M. The changing epidemiology of healthcare-associated candidemia over three decades. Diagn. Microbiol. Infect. Dis. 2012, 73, 45–48. [Google Scholar] [CrossRef]
- Caggiano, G.; Coretti, C.; Bartolomeo, N.; Lovero, G.; De Giglio, O.; Montagna, M.T. Candida Bloodstream Infections in Italy: Changing Epidemiology during 16 Years of Surveillance. BioMed Res. Int 2015. [Google Scholar] [CrossRef]
- Antinori, S.; Nebuloni, M.; Magni, C.; Fasan, M.; Adorni, F.; Viola, A.; Corbellino, M.; Galli, M.; Vago, G.; Parravicini, C.; et al. Trends in the postmortem diagnosis of opportunistic invasive fungal infections in patients with AIDS: A retrospective study of 1630 autopsies performed between 1984 and 2002. Am. J. Clin. Pathol. 2009, 132, 221–227. [Google Scholar] [CrossRef]
- Guinea, J.; Torres-Narbona, M.; Gijón, P.; Muñoz, P.; Pozo, F.; Peláez, T.; De Miguel, J.; Bouza, E. Pulmonary aspergillosis in patients with chronic obstructive pulmonary disease: Incidence, risk factors, and outcome. Clin. Microbiol. Infect. 2010, 16, 870–877. [Google Scholar] [CrossRef]
- Montagna, M.T.; Lovero, G.; Coretti, C.; Martinelli, D.; Delia, M.; De Giglio, O.; Caira, M.; Puntillo, F.; D’Antonio, D.; Venditti, M.; et al. SIMIFF study: Italian fungal registry of mold infections in hematological and non-hematological patients. Infection 2014, 42, 141–151. [Google Scholar] [CrossRef]
- Antoniadou, A. Outbreaks of zygomycosis in hospitals. Clin. Microbiol. Infect. 2009, 15, 55–59. [Google Scholar] [CrossRef]
- Kanamori, H.; Rutala, W.A.; Sickbert-Bennett, E.E.; Weber, D.J. Review of fungal outbreaks and infection prevention in healthcare settings during construction and renovation. Clin. Infect. Dis. 2015, 61, 433–444. [Google Scholar] [CrossRef]
- Giudice, G.; Cutrignelli, D.A.; Sportelli, P.; Limongelli, L.; Tempesta, A.; Gioia, G.D.; Santacroce, L.; Maiorano, E.; Favia, G. Rhinocerebral Mucormycosis with Orosinusal Involvement: Diagnostic and Surgical Treatment Guidelines. Endocr. Metab. Immune. Disord. Drug Targets 2016, 16, 264–269. [Google Scholar] [CrossRef]
- Kanamori, H.; Weber, D.J.; Rutala, W.A. Healthcare outbreaks associated with a water reservoir and infection prevention strategies. Clin. Infect. Dis. 2016, 62, 1423–1435. [Google Scholar] [CrossRef]
- Seidel, D.; Meißner, A.; Lackner, M.; Piepenbrock, E.; Salmanton-García, J.; Stecher, M.; Mellinghoff, S.; Hamprecht, A.; Graeff, L.D.; Köhler, P.; et al. Prognostic factors in 264 adults with invasive Scedosporium spp. and Lomentospora prolificans infection reported in the literature and FungiScope®. Crit. Rev. Microbiol. 2019, 45, 1–21. [Google Scholar] [CrossRef]
- Mesquita-Rocha, S.; Godoy-Martinez, P.C.; Gonçalves, S.S.; Urrutia, M.D.; Carlesse, F.; Seber, A.; Silva, M.A.; Petrilli, A.S.; Colombo, A.L. The water supply system as a potential source of fungal infection in paediatric haematopoietic stem cell units. BMC Infect. Dis. 2013, 13, 289. [Google Scholar] [CrossRef]
- Caggiano, G.; Napoli, C.; Coretti, C.; Lovero, G.; Scarafile, G.; De Giglio, O.; Montagna, M.T. Mold contamination in a controlled hospital environment: A 3-year surveillance in southern Italy. BMC Infect. Dis. 2014, 14, 595. [Google Scholar] [CrossRef]
- Montagna, M.T.; Rutigliano, S.; Trerotoli, P.; Napoli, C.; Apollonio, F.; D’Amico, A.; De Giglio, O.; Diella, G.; Lopuzzo, M.; Marzella, A.; et al. Evaluation of Air Contamination in Orthopaedic Operating Theatres in Hospitals in Southern Italy: The IMPACT Project. Int. J. Environ. Res. Public Health 2019, 16, 3581. [Google Scholar] [CrossRef]
- Arvanitidou, M.; Kanellou, K.; Constantinides, T.C.; Katsouyannopoulos, V. The occurrence of fungi in hospital and community potable waters. Lett. Appl. Microbiol. 1999, 29, 81–84. [Google Scholar] [CrossRef]
- Siqueira, V.M. Characterising Filamentous Fungal Biofilm in Drinking Water Distribution Systems Using Microscopic and Molecular Techniques. Ph.D. Thesis, Universidade do Minho, Braga, Portugal, 2011. [Google Scholar]
- De Giglio, O.; Barbuti, G.; Trerotoli, P.; Brigida, S.; Calabrese, A.; Di Vittorio, G.; Lovero, G.; Caggiano, G.; Uricchio, V.F.; Montagna, M.T. Microbiological and hydrogeological assessment of groundwater in southern Italy. Environ. Monit. Assess. 2016, 188, 638. [Google Scholar] [CrossRef]
- De Giglio, O.; Caggiano, G.; Bagordo, F.; Barbuti, G.; Brigida, S.; Lugoli, F.; Grassi, T.; La Rosa, G.; Lucentini, L.; Uricchio, V.F.; et al. Enteric Viruses and Fecal Bacteria Indicators to Assess Groundwater Quality and Suitability for Irrigation. Int. J. Environ. Res. Public Health 2017, 14, 558. [Google Scholar] [CrossRef]
- Masciopinto, C.; De Giglio, O.; Scrascia, M.; Fortunato, F.; La Rosa, G.; Suffredini, E.; Pazzani, C.; Prato, R.; Montagna, M.T. Human health risk assessment for the occurrence of enteric viruses in drinking water from wells: Role of flood runoff injections. Sci. Total Environ. 2019, 666, 559–571. [Google Scholar] [CrossRef]
- Montagna, M.T.; De Giglio, O.; Napoli, C.; Lovero, G.; Caggiano, G.; Delia, M.; Pastore, D.; Santoro, N.; Specchia, G. Invasive fungal infections in patients with hematologic malignancies (aurora project): Lights and shadows during 18-months surveillance. Int. J. Mol. Sci. 2012, 13, 774–787. [Google Scholar] [CrossRef]
- Montagna, M.T.; Caggiano, G.; Lovero, G.; De Giglio, O.; Coretti, C.; Cuna, T.; Iatta, R.; Giglio, M.; Dalfino, L.; Bruno, F.; et al. Epidemiology of invasive fungal infections in Intensive Care Unit: Results of a multicenter Italian survey (AURORA Project). Infection 2013, 41, 645–653. [Google Scholar] [CrossRef]
- Mhlongo, N.T.; Tekere, M.; Sibanda, T. Prevalence and Public Health Implications of Mycotoxigenic Fungi in Treated Drinking Water Systems. J. Water Health 2019, 17, 517–531. [Google Scholar] [CrossRef]
- Anaissie, E.J.; Stratton, S.L.; Dignani, M.C.; Lee, C.K.; Summerbell, R.C.; Rex, J.H.; Monson, T.P.; Spencer, T.; Kasai, M.; Francesconi, A.; et al. Pathogenic Aspergillus species recovered from a hospital water system: A 3-year prospective study. Clin. Infect. Dis. 2001, 34, 780–789. [Google Scholar] [CrossRef]
- Pereira, V.J.; Fernandes, D.; Carvalho, G.; Benoliel, M.J.; San Romao, M.V.; Crespo, M.T.B. Assessment of the presence and dynamics of fungi in drinking water sources using cultural and molecular methods. Water Res. 2010, 44, 4850–4859. [Google Scholar] [CrossRef]
- Doggett, M.S. Characterization of fungal biofilms within a municipal water distribution system. Appl. Environ. Microbiol. 2000, 66, 1249–1251. [Google Scholar] [CrossRef]
- Hageskal, G.; Knutsen, A.K.; Gaustad, P.; Hoog, G.S.; Skaar, I. Diversity and significance of mold species in norwegian drinking water. Appl. Environ. Microbiol. 2006, 72, 7586–7593. [Google Scholar] [CrossRef]
- Sammon, N.B.; Harrower, K.M.; Fabbro, L.D.; Reed, R.H. Incidence and distribution of microfungi in a treated municipal water supply system in sub-tropical Australia. Int. J. Environ. Res. Public Health 2010, 7, 1597–1611. [Google Scholar] [CrossRef]
- Al-Gabr, H.M.; Zheng, T.; Yu, X. Occurrence and quantification of fungi and detection of mycotoxigenic fungi in drinking water in Xiamen City, China. Sci. Total Environ. 2014, 466–467, 1103–1111. [Google Scholar] [CrossRef]
- Niemi, R.M.; Knuth, S.; Lundstrom, K. Actinomycetes and € fungi in surface waters and in potable water. Appl. Environ. Microbiol. 1982, 43, 378–388. [Google Scholar] [CrossRef]
- Ma, X.; Baron, J.L.; Vikram, A.; Stout, J.E.; Bibby, K. Fungal Diversity and Presence of Potentially Pathogenic Fungi in a Hospital Hot Water System Treated with On-Site Monochloramine. Water Res. 2015, 71, 197–206. [Google Scholar] [CrossRef] [PubMed]
- Åslund, P. Skin irritations caused by moulds (in Swedish). Vår Föda 1984, 36, 327–336. [Google Scholar]
- Muittari, A.; Kuusisto, P.; Virtanen, P.; Sovijärvi, A.; Grönroos, P.; Harmoinen, A.; Antila, P.; Kellomäki, L. An epidemic of extrinsic allergic alveolitis caused by tap water. Clin. Allergy 1980, 10, 77–90. [Google Scholar] [CrossRef] [PubMed]
- Hageskal, G.; Lima, N.; Skaar, I. The study of fungi in drinking water. Mycol. Res. 2009, 113 Pt 2, 165–172. [Google Scholar] [CrossRef]
- Decreto Legislativo 2 Febbraio 2001, n. 31. Attuazione Della Direttiva 98/83/CE Relativa alla Qualità Delle Acque Destinate al Consumo Umano. Gazzetta Ufficiale n. 52 del 3 Marzo 2001—Supplemento Ordinario n. 41. Available online: https://www.camera.it/parlam/leggi/deleghe/01031dl.htm (accessed on 10 January 2020).
- Decreto Legislativo 2 febbraio 2002, n. 27. Modifiche ed Integrazioni al Decreto Legislativo 2 febbraio 2001, n. 31, Recante Attuazione della Direttiva 98/83/CE Relativa alla Qualità delle Acque Destinate al Consumo Umano. Gazzetta Ufficiale Serie Generale n.58 del 09-03-2002. Available online: https://www.gazzettaufficiale.it/atto (accessed on 10 January 2020).
- European Commission. Proposal for a Directive of the European Parliament and of the Council on the Quality of Water Intended for Human Consumption (recast) COM/2017/0753 final—2017/0332 (COD). Available online: https://eur-lex.europa.eu/legal-content/EN/TXT/HTML/?uri=CELEX:52017PC0753&from=EN (accessed on 31 July 2020).
- Babič, M.N.; Zalar, P.; Ženko, B.; Džeroski, S.; Gunde-Cimerman, N. Yeasts and yeast-like fungi in tap water and groundwater, and their transmission to household appliances. Fungal Ecol. 2016, 20, 30–39. [Google Scholar] [CrossRef]
- Fuiano, G.; Alloatti, S.; Bolasco, P.; Canavese, C.; Cappelli, G.; Pedrini, L.; Pizzarelli, F.; Pontoriero, G. Linee Guida su acque e soluzioni per dialisi. G. Ital. Nefrol. 2005, 22, 246–273. [Google Scholar]
- Kauffmann-Lacroix, C.; Costa, D.; Imbert, C. Fungi, Water Supply and Biofilms. Adv. Exp. Med. Biol. 2016. [Google Scholar] [CrossRef]
- Babič, M.N.; Gunde-Cimerman, N.; Vargha, M.; Tischner, Z.; Magyar, D.; Veríssimo, C.; Sabino, R.; Viegas, C.; Meyer, W.; Brandão, J. Fungal contaminants in drinking water regulation? A tale of ecology, exposure, purification and clinical relevance. Int. J. Environ. Res. Public Health 2017, 14, 636. [Google Scholar] [CrossRef]
- Sonigo, P.; De Toni, A.; Reilly, K. A Review of Fungi in Drinking Water and the Implications for Human Health. Final Report WD 0906; Bio Intelligence Service: Paris, France, 2011. [Google Scholar]
- Caggiano, G.; Lovero, G.; De Giglio, O.; Barbuti, G.; Montagna, O.; Laforgia, N.; Montagna, M.T. Candidemia in the Neonatal Intensive Care Unit: A Retrospective, Observational Survey and Analysis of Literature Data. BioMed Res. Int. 2017. [Google Scholar] [CrossRef]
- Etienne, K.A.; Subudhi, C.P.K.; Chadwick, P.R.; Settle, P.; Moise, J.; Magill, S.S.; Chiller, T.; Balajee, S.A. Investigation of a cluster of cutaneous aspergillosis in a neonatal intensive care unit. J. Hosp. Infect. 2011, 79, 344–348. [Google Scholar] [CrossRef]
- Lovero, G.; Giglio, O.; Rutigliano, S.; Diella, G.; Caggiano, G.; Montagna, M.T. In vitro antifungal susceptibilities of Candida species to liposomal amphotericin B, determined using CLSI broth microdilution, and amphotericin B deoxycholate, measured using the Etest. J. Med. Microbiol. 2017, 66, 213–216. [Google Scholar] [CrossRef] [PubMed]
- Pires-Gonçalves, R.H.; Sartori, F.G.; Montanari, L.B.; Zaia, J.E.; Melhem, M.S.C.; Mendes-Giannini, M.J.S.; Martins, C.H.G. Occurrence of Fungi in Water Used at a Haemodialysis Centre. Lett. Appl. Microbiol. 2008, 46, 542–547. [Google Scholar] [CrossRef] [PubMed]
- Kim, H.A.; Hyun, M.; Ryu, S.Y. Catheter-Associated Rhodotorula mucilaginosa Fungemia in an Immunocompetent Host. Infect. Chemother. 2013, 45, 339–342. [Google Scholar] [CrossRef] [PubMed]
- Pitt, J.I.; Bacilico, J.C.; Abarca, M.L.; Lopez, C. Mycotoxins and toxigenic fungi. Med. Mycol. 2000, 38, 41–46. [Google Scholar] [CrossRef]
- Bhat, R.; Rai, R.V.; Karim, A.A. Mycotoxins in food and feed: Present status and future concerns. Compr. Rev. Food Sci. Food Saf. 2010, 9, 57–81. [Google Scholar] [CrossRef]
- Magwaza, N.; Nxumalo, E.N.; Mamba, B.B.; Msagati, T.A.M. The occurrence and diversity of waterborne fungi in African aquatic systems: Their impact on water quality and human health. Int. J. Environ. Res. Public Health 2017, 14, 546. [Google Scholar] [CrossRef]
- Grabińska-Łoniewska, A.; Koniłłowicz-Kowalska, T.; Wardzyńska, G.; Boryn, K. Occurrence of fungi in water distribution system. Pol. J. Environ. Stud. 2007, 16, 539–547. [Google Scholar]
- De Hoog, G.S.; Guarro, J.; Gené, J.; Figueras, M.J.; Vitale, R.G. Atlas of Clinical Fungi: Electronic Version 3.1; Centraalbureau voor Schimmelcultures (CBS): Utrecht, The Netherlands, 2019; Available online: http://www.clinicalfungi.org (accessed on 31 July 2020).

| Fungal Genera | Surgery (No = 52) | Intensive Care (No = 27) | Medicine (No = 103) | Intermediate Service (No = 19) | Others (No = 6) | Total (No = 207) | ||||||
|---|---|---|---|---|---|---|---|---|---|---|---|---|
| No | % | No | % | No | % | No | % | No | % | No | % | |
| Fusarium | 5 | 9.62 | 4 | 14.81 | 33 | 32.04 | 9 | 47.37 | 1 | 16.67 | 52 | 25.12 |
| Aspergillus | 12 | 23.08 | 7 | 25.93 | 19 | 18.45 | 3 | 15.79 | 0 | - | 41 | 19.81 |
| Cladosporium | 6 | 11.54 | 3 | 11.11 | 22 | 21.36 | 2 | 10.53 | 4 | 66.67 | 37 | 17.87 |
| Penicillium | 5 | 9.62 | 3 | 11.11 | 15 | 14.56 | 1 | 5.26 | 1 | 16.67 | 25 | 12.08 |
| Acremonium | 6 | 11.54 | 2 | 7.41 | 16 | 15.53 | 0 | - | 0 | - | 24 | 11.59 |
| Paecilomyces | 11 | 21.15 | 3 | 11.11 | 3 | 2.91 | 0 | - | 0 | - | 17 | 8.21 |
| Rhodotorula | 3 | 5.77 | 5 | 18.52 | 6 | 5.83 | 0 | - | 0 | - | 14 | 6.76 |
| Alternaria | 6 | 11.54 | 1 | 3.70 | 5 | 4.85 | 1 | 5.26 | 0 | - | 13 | 6.28 |
| Mucorales | 3 | 5.77 | 0 | - | 8 | 7.77 | 1 | 5.26 | 1 | 16.67 | 13 | 6.28 |
| Chrysosporium | 0 | - | 1 | 3.70 | 3 | 2.91 | 3 | 15.79 | 0 | - | 7 | 3.38 |
| Scedosporium | 1 | 1.92 | 2 | 7.41 | 1 | 0.97 | 0 | - | 0 | - | 4 | 1.93 |
| Scopulariopsis | 0 | - | 1 | 3.70 | 1 | 0.97 | 2 | 10.53 | 0 | - | 4 | 1.93 |
| Trichophyton | 1 | 1.92 | 0 | - | 2 | 1.94 | 1 | 5.26 | 0 | - | 4 | 1.93 |
| Exophiala | 2 | 3.85 | 1 | 3.70 | 0 | - | 0 | - | 0 | - | 3 | 1.45 |
| Microsporum | 3 | 5.77 | 0 | - | 0 | - | 0 | - | 0 | - | 3 | 1.45 |
| Monilia | 3 | 5.77 | 0 | - | 0 | - | 0 | - | 0 | - | 3 | 1.45 |
| Cryptococcus | 0 | - | 1 | 3.70 | 2 | 1.94 | 0 | - | 0 | - | 3 | 1.45 |
| Verticillium | 0 | - | 0 | - | 2 | 1.94 | 0 | - | 0 | - | 2 | 0.97 |
| Candida | 1 | 1.92 | 1 | 3.70 | 0 | - | 0 | - | 0 | - | 2 | 0.97 |
| Moniliella | 0 | - | 0 | - | 0 | - | 1 | 5.26 | 0 | - | 1 | 0.48 |
| Trichoderma | 1 | 1.92 | 0 | - | 0 | - | 0 | - | 0 | - | 1 | 0.48 |
| Surgery (No = 91) | Intensive Care (No = 31) | Medicine (No = 209) | Intermediate Service (No = 23) | Others (No = 10) | Total (No = 364) | |||||||
|---|---|---|---|---|---|---|---|---|---|---|---|---|
| No | % | No | % | No | % | No | % | No | % | No | % | |
| Total samples | ||||||||||||
| Positive | 52 | 57.14 | 27 | 87.10 | 103 | 49.28 | 19 | 82.61 | 6 | 60.00 | 207 | 56.87 |
| Negative | 39 | 42.86 | 4 | 12.90 | 106 | 50.72 | 4 | 17.39 | 4 | 40.00 | 157 | 43.13 |
| Molds | ||||||||||||
| Positive | 49 | 53.85 | 23 | 74.19 | 98 | 46.89 | 19 | 82.61 | 4 | 40.00 | 195 | 53.57 |
| Negative | 42 | 46.15 | 8 | 25.81 | 111 | 53.11 | 4 | 17.39 | 6 | 60.00 | 169 | 46.43 |
| Yeasts | ||||||||||||
| Positive | 4 | 4.40 | 7 | 22.58 | 8 | 3.83 | 0 | 0.00 | 0 | 0.00 | 19 | 5.22 |
| Negative | 87 | 95.60 | 24 | 77.42 | 201 | 96.17 | 23 | 100.00 | 10 | 100.00 | 345 | 94.78 |
| Bathrooms (No = 66) | Hospital Rooms (No = 104) | Operatory Rooms (No = 73) | Others (No = 121) | Total (No = 364) | ||||||
|---|---|---|---|---|---|---|---|---|---|---|
| No | % | No | % | No | % | No | % | No | % | |
| Total samples | ||||||||||
| Positive | 38 | 57.58 | 65 | 62.5 | 40 | 54.79 | 64 | 52.89 | 207 | 56.87 |
| Negative | 28 | 42.42 | 39 | 37.5 | 33 | 45.21 | 57 | 47.11 | 157 | 43.13 |
| Molds research | ||||||||||
| Positive | 37 | 56.06 | 61 | 58.65 | 38 | 52.05 | 59 | 48.76 | 195 | 53.57 |
| Negative | 29 | 43.94 | 43 | 41.35 | 35 | 47.95 | 62 | 51.24 | 169 | 46.43 |
| Yeasts research | ||||||||||
| Positive | 1 | 1.52 | 9 | 8.65 | 2 | 2.74 | 7 | 5.79 | 19 | 5.22 |
| Negative | 65 | 98.48 | 95 | 91.35 | 71 | 97.26 | 114 | 94.21 | 345 | 94.78 |
© 2020 by the authors. Licensee MDPI, Basel, Switzerland. This article is an open access article distributed under the terms and conditions of the Creative Commons Attribution (CC BY) license (http://creativecommons.org/licenses/by/4.0/).
Share and Cite
Caggiano, G.; Diella, G.; Triggiano, F.; Bartolomeo, N.; Apollonio, F.; Campanale, C.; Lopuzzo, M.; Montagna, M.T. Occurrence of Fungi in the Potable Water of Hospitals: A Public Health Threat. Pathogens 2020, 9, 783. https://doi.org/10.3390/pathogens9100783
Caggiano G, Diella G, Triggiano F, Bartolomeo N, Apollonio F, Campanale C, Lopuzzo M, Montagna MT. Occurrence of Fungi in the Potable Water of Hospitals: A Public Health Threat. Pathogens. 2020; 9(10):783. https://doi.org/10.3390/pathogens9100783
Chicago/Turabian StyleCaggiano, Giuseppina, Giusy Diella, Francesco Triggiano, Nicola Bartolomeo, Francesca Apollonio, Carmen Campanale, Marco Lopuzzo, and Maria Teresa Montagna. 2020. "Occurrence of Fungi in the Potable Water of Hospitals: A Public Health Threat" Pathogens 9, no. 10: 783. https://doi.org/10.3390/pathogens9100783
APA StyleCaggiano, G., Diella, G., Triggiano, F., Bartolomeo, N., Apollonio, F., Campanale, C., Lopuzzo, M., & Montagna, M. T. (2020). Occurrence of Fungi in the Potable Water of Hospitals: A Public Health Threat. Pathogens, 9(10), 783. https://doi.org/10.3390/pathogens9100783

